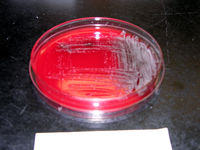

Science Fair 2009 |
Lizzy and Sarah |
Both Lizzy and Sarah participated
in the Science Fair this year with cute and interesting research. Lizzy wanted
to find out which had a dirtier mouth, dogs or humans. She swabbed the mouths
of 3 dogs and 3 humans. She took the swabs to the old hospital where the microbiology
lab personnel taught her how to swab and preserve the petri dishes. She returned
to the lab in 24 and 48 hours to check on and photograph the growth of bacteria
in the petri dishes. The human mouths profoundly had more bacteria than the
dogs mouths did. Emma's famous quote is, "Can you believe that my mom
has a dirtier mouth than Kevin (family dog); and he eats poop and everything!".
Sarah's research also involved dogs. She wanted to determine if dogs were
more frequently right-pawed or left-pawed. She went around the neighborhood
and asked the owners to shake paws with their dogs while she recorded which
paw each dog shook with. She was glad to discover that 60% of the dogs were
left-pawed. She was glad because she is left-handed! Sarah won 1st place for
the firts grade in her school, qualifying her to go to the district science
fair. Look at the pictures below to see some of the pictures of their experiments.
Click on any to view a larger version.
Lizzy_A.jpg |

Lizzy_A2.jpg |

Lizzy_B.jpg |

Lizzy_C.jpg |

Lizzy_D.jpg |

Lizzy_E.jpg |

Sarah_A.jpg |

Sarah_B.jpg |

Sarah_C.jpg |

Sarah_D.jpg |

Sarah_E.jpg |

Sarah_F.jpg |

Sarah_G.jpg |

Sarah_H.jpg |